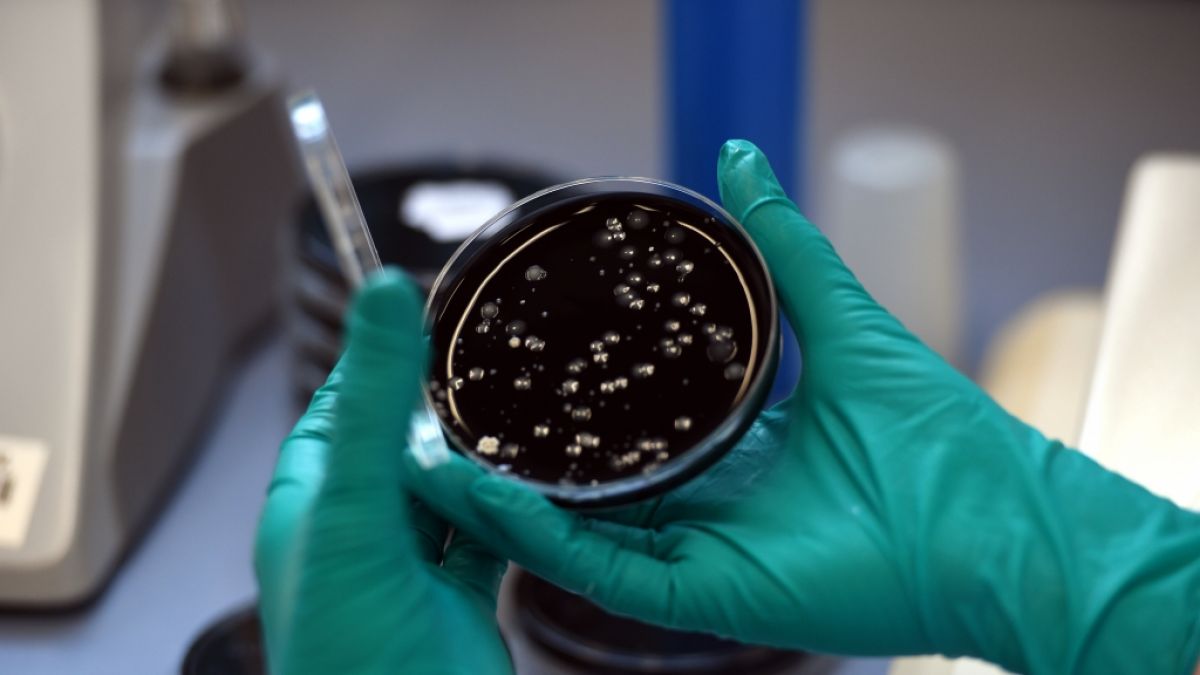
In London wurden zwei F&auml;lle der Legion&auml;rskrankheit gemeldet. (Foto)

Legionellose: Rätsel um Ausbruch von fataler Legionärskrankheit
Zwei Ausbrüche der Legionärskrankheit halten London in Atem – die Gesundheitsbehörden rätseln noch, ob die Fälle aus derselben Quelle stammen. Gibt es einen Grund zur Sorge? Darauf sollten Sie bei einer Infektion achten.
Erstellt von Sabrina Böhme - Uhr
Suche
Suche
- Legionärskrankheit in London ausgebrochen
- Legionellen können Legionärskrankheit auslösen
- Schwere Symptome durch Infektion
Eine Infektionskrankheit beschäftigt aktuell die britische Gesundheitsbehörde UKHSA. In der britischen Hauptstadt sind zwei Ausbrüche der Legionärskrankheit aufgetreten. Die Fälle wurden sowohl im Nordwesten als auch im Südwesten Londons registriert.
Fatale Infektion: Legionärskrankheit in London
UKHSA hat Ermittlungen eingeleitet, um die Infektionsquelle zu identifizieren. Bislang ist unklar, ob zwischen den beiden Ausbrüchen ein Zusammenhang besteht. Die genaue Anzahl der Betroffenen wurde nicht bekannt gegeben. "Eine gemeinsame Quelle wurde bisher noch nicht bestätigt, aber wir führen mit unseren Partnern weitere Untersuchungen durch, die uns mehr Informationen liefern werden", zitiert das Nachrichtenportal "Metro" Dr. Janice Lo, Beraterin für Gesundheitsschutz bei der UKHSA London.
Gefährliche Bakterien in Wassersystemen
Auslöser der gemeldeten Erkrankung sind Legionellen. Die Bakterien können in die Lunge eindringen und dort die Legionärskrankheit auslösen. Es handelt sich hierbei um eine Form der Lungenentzündung. Menschen infizieren sich, wenn sie winzige Wassertröpfchen einatmen, die mit den auslösenden Bakterien kontaminiert sind. Besonders häufig finden sich die Erreger in größeren Wassersystemen von Gebäuden. Klimaanlagen, Luftbefeuchter, Whirlpools sowie selten benutzte Wasserhähne und Duschen gelten als typische Infektionsquellen. Infektionen treten sehr selten in Pflegeeinrichtungen auf. Häufiger sind Fälle im Zusammenhang mit Reisen, schreibt der Lungeninformationsdienst.
"Legionella-Bakterien sind in der Umwelt weit verbreitet und können sich in großen Wassersystemen innerhalb von Gebäuden vermehren", betonte Dr. Lo. Eine ordnungsgemäße Wartung mit regelmäßigen Tests und Behandlungen sei entscheidend, um eine Vermehrung der Bakterien zu verhindern und Gesundheitsrisiken auszuschließen.
Legionellen: Symptome als Warnsignal
Erkrankte entwickeln typischerweise Beschwerden, die einer Grippe ähneln. Folgende Symptome können auf die Infektionskrankheit hinweisen:
- Muskelschmerzen
- starke Erschöpfung
- Kopfschmerzen
- trockener Husten
- Fieber
Hinweis: Die Beschwerden können auch auf andere Krankheiten hinweisen. Dennoch sollten Betroffene die Symptome ärztlich abklären lassen.
Die Behandlung erfolgt in der Regel mit Antibiotika. Die meisten Patienten erholen sich innerhalb weniger Wochen vollständig von der Infektion. Dennoch kann die Erkrankung in schweren Fällen lebensbedrohlich verlaufen – es erfordert daher eine frühzeitige medizinische Versorgung. Es handelt sich bei einer Legionellose um eine meldepflichtige Krankheit, schreibt das Robert-Koch-Institut (RKI). Größere Ausbrüche sind eher selten.
Legionellose: Rund 300 Fälle jährlich in England und Wales
Die UKHSA verzeichnet pro Jahr etwa 300 Infektionen mit der Legionärskrankheit in England und Wales. Die meisten Fälle treten einzeln und isoliert auf, doch Ausbrüche wie der aktuelle in London kommen vor.
In der Vergangenheit sorgten mehrere Vorfälle für Aufsehen. Im Jahr 2023 mussten 39 Asylbewerber von der Bibby Stockholm evakuiert werden, nachdem Legionella-Bakterien in der Wasserversorgung des Unterkunftsschiffs entdeckt worden waren. Ein Häftling im Gefängnis HMP Lincoln verstarb nach einer Infektion mit der Krankheit. Wasserproben aus seiner Zelle und den Duschräumen wiesen die Erreger nach – ein Dienstleister wurde später zu einer Geldstrafe von 600.000 Pfund verurteilt.
Diese Gesundheitsthemen könnten Sie ebenfalls interessieren:
- Experten zeigen sich besorgt - diese Viren könnten die nächste Pandemie auslösen
- Institut warnt - Vogelgrippe-Pandemie könnte schlimmer sein als Covid
- Kardiologin über das stille Risiko im Alter - so schützen Sie Ihr Herz
- Die unterschätzte Gefahr - deshalb sollten Sie schnell reagieren
bos/loc/news.de/stg
Erfahren Sie hier mehr über die journalistischen Standards und die Redaktion von news.de.